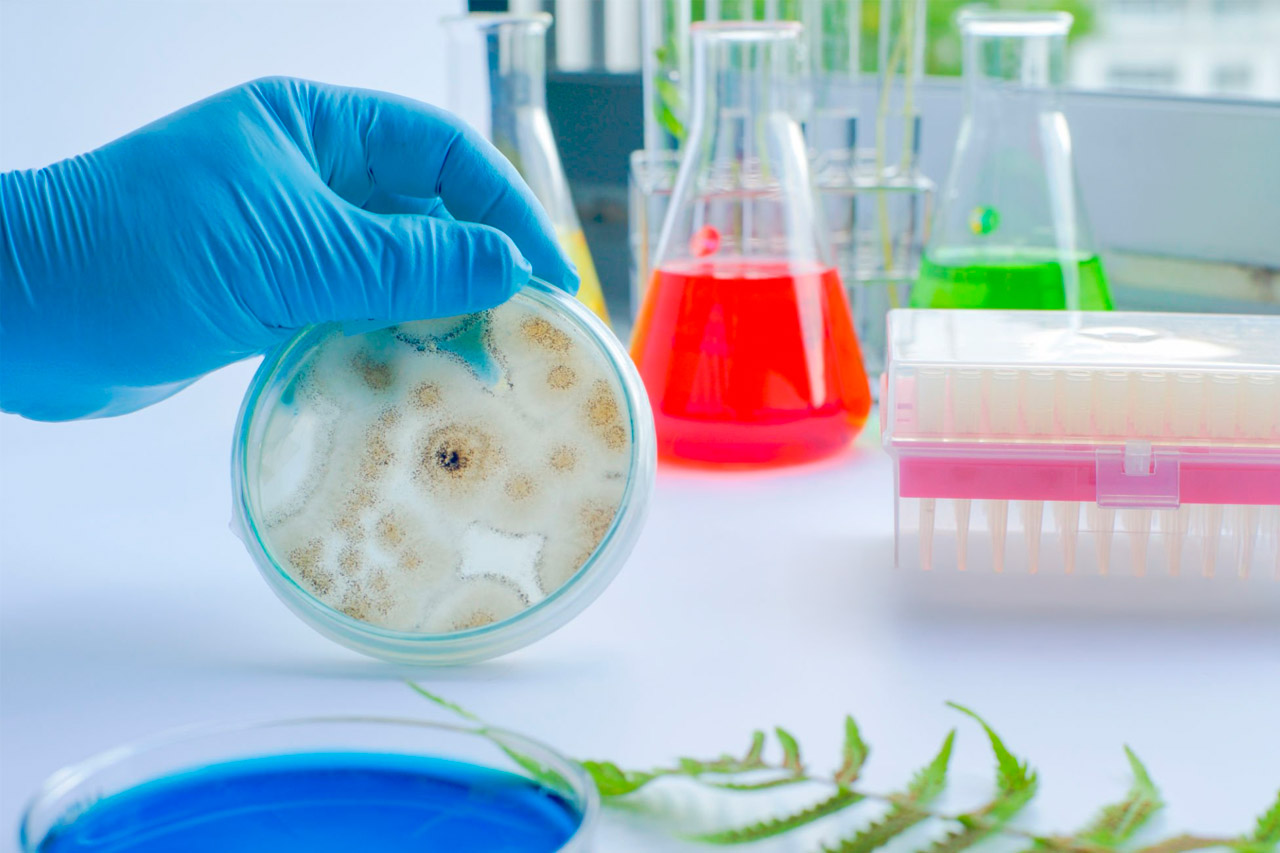

Publicaciones
Revista Científica de Innovación, Desarrollo Rural y Sostenibilidad Agropecuaria.
La Nueva Universidad Agraria
Formamos parte de una comunidad global que busca respuestas a las preguntas más grandes del mañana. La investigación es el núcleo de nuestro espíritu.
Descubre Nuestros Proyectos